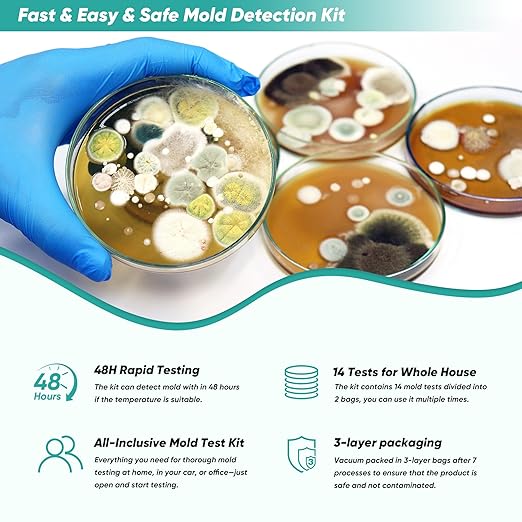
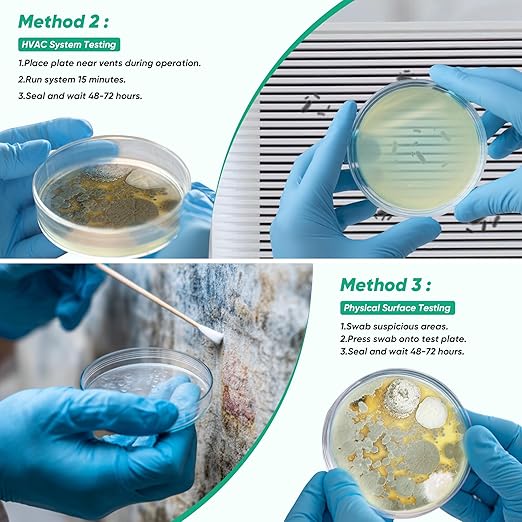

Jhomon
Mold Test Kit for Home, 14 Simple Mold Detectors with Detailed Mold Identification Guide, DIY Mold Testing Kit for Home Surfaces & Indoor Air Quality & HVAC & Car, Results in 48 Hours, 14PCS
Mold Test Kit for Home, 14 Simple Mold Detectors with Detailed Mold Identification Guide, DIY Mold Testing Kit for Home Surfaces & Indoor Air Quality & HVAC & Car, Results in 48 Hours, 14PCS
Couldn't load pickup availability
About This
- Why Choose Our Mold Test Kit: Mold is the invisible intruder invading your safe space. Our mold test kit for home can Identify potential mold hotspots in your home, car, or HVAC system within 48–72 hours, and help you take swift action to maintain a mold-free environment.
- Complete All-in-One Kit: Our mold test kit includes 14 test plates (3-layer sealed package, 2 packs of 7), swabs, gloves & detailed guide - everything needed for thorough mold testing in your home, car or office. Test walls, HVAC, furniture & air quality simultaneously with this comprehensive solution.
- Sterile Manufacturing for Maximum Accuracy: All petri dishes are produced and sealed in a sterile environment to ensure optimal culture activity, guaranteeing reliable and accurate test results. With a simple 3-step process—expose, incubate, compare—you’ll get clear, visible results without complicated procedures. Even beginners can perform professional-grade testing with ease.
- Lab-Accurate Results + Free Expert Analysis: After 48-72 hours of incubation, use the included guide to recognize common molds, or email photos for free professional identification and customized mold cleaning & preventive measures. (A small amount of condensation within the completely sealed package is normal and will not affect the product's performance or usability).
- Cost-Effective Alternative to Professional Inspections: Save hundreds compared to 300−500 professional inspections. Our affordable mold detector for home provides 14 tests (enough for 2 whole-home inspections) with lab-quality accuracy. Early detection prevents security issues and costly repairs.